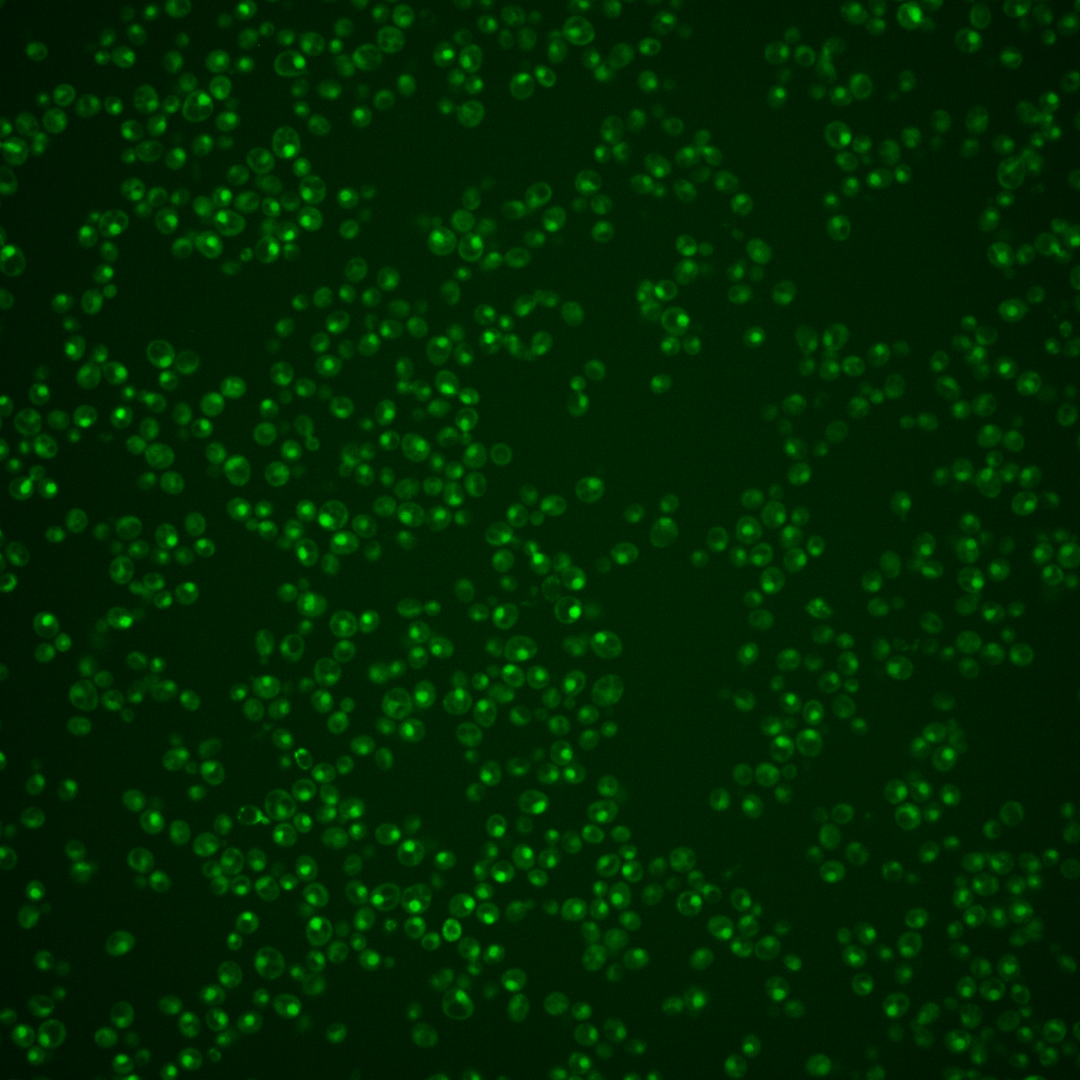

| Standard name | |
|---|---|
| Human Ortholog | |
| Description | Splicing factor; component of the U4/U6-U5 snRNP complex |
Micrographs




















































































Sub-cellular Localization
Yeast GFP Assignment
Protein Abundance
Localization Change
External localization resources
| ensLOC | DeepLoc | |||||||||||||||||||||||
|---|---|---|---|---|---|---|---|---|---|---|---|---|---|---|---|---|---|---|---|---|---|---|---|---|
| Localization | WT1 | WT2 | WT3 | RAP60 | RAP140 | RAP220 | RAP300 | RAP380 | RAP460 | RAP540 | RAP620 | RAP700 | HU80 | HU120 | HU160 | rpd3Δ_1 | rpd3Δ_2 | rpd3Δ_3 | WT1 | WT2 | WT3 | AF100 | AF140 | AF180 |
| Cortical Patches | 0 | 0 | 0 | 0 | 0 | 0 | 1 | 0 | 0 | 0 | 0 | 0 | 1 | 0 | 0 | 0 | 0 | 0 | 0 | 0 | 0 | 1 | 0 | 1 |
| Bud | 0 | 0 | 0 | 0 | 1 | 0 | 0 | 1 | 0 | 0 | 3 | 0 | 1 | 0 | 2 | 2 | 1 | 0 | 2 | 3 | 0 | 3 | 2 | 6 |
| Bud Neck | 0 | 0 | 0 | 0 | 0 | 0 | 0 | 1 | 0 | 0 | 1 | 2 | 0 | 0 | 0 | 0 | 0 | 1 | 0 | 0 | 0 | 0 | 1 | 2 |
| Bud Site | 0 | 0 | 0 | 0 | 1 | 2 | 5 | 3 | 2 | 1 | 7 | 0 | 1 | 0 | 0 | 0 | 0 | 1 | – | – | – | – | – | – |
| Cell Periphery | 0 | 0 | 0 | 1 | 0 | 3 | 0 | 0 | 0 | 0 | 0 | 0 | 0 | 0 | 0 | 1 | 1 | 2 | 0 | 0 | 0 | 0 | 0 | 0 |
| Cytoplasm | 12 | 5 | 7 | 10 | 8 | 15 | 12 | 11 | 10 | 5 | 6 | 6 | 21 | 39 | 54 | 57 | 66 | 54 | 1 | 0 | 1 | 0 | 1 | 1 |
| Endoplasmic Reticulum | 1 | 0 | 0 | 0 | 0 | 0 | 1 | 1 | 0 | 0 | 0 | 1 | 1 | 1 | 0 | 16 | 26 | 28 | 0 | 0 | 0 | 0 | 1 | 1 |
| Endosome | 0 | 0 | 0 | 0 | 1 | 2 | 0 | 2 | 0 | 0 | 0 | 0 | 0 | 1 | 1 | 2 | 9 | 4 | 4 | 0 | 0 | 0 | 1 | 5 |
| Golgi | 0 | 0 | 0 | 0 | 1 | 1 | 0 | 0 | 0 | 0 | 0 | 0 | 0 | 0 | 0 | 1 | 1 | 0 | 0 | 1 | 0 | 0 | 1 | 2 |
| Mitochondria | 35 | 34 | 7 | 3 | 3 | 12 | 37 | 27 | 20 | 51 | 62 | 24 | 26 | 13 | 6 | 38 | 29 | 58 | 0 | 1 | 0 | 1 | 1 | 4 |
| Nucleus | 262 | 187 | 91 | 78 | 83 | 64 | 92 | 76 | 45 | 53 | 85 | 60 | 325 | 382 | 316 | 337 | 421 | 369 | 251 | 181 | 83 | 263 | 240 | 236 |
| Nuclear Periphery | 0 | 0 | 0 | 0 | 1 | 2 | 0 | 1 | 0 | 0 | 2 | 0 | 0 | 5 | 2 | 0 | 0 | 3 | 0 | 0 | 0 | 0 | 0 | 1 |
| Nucleolus | 1 | 0 | 1 | 0 | 0 | 0 | 3 | 2 | 0 | 1 | 4 | 2 | 1 | 6 | 6 | 0 | 3 | 0 | 2 | 0 | 0 | 5 | 8 | 20 |
| Peroxisomes | 0 | 0 | 0 | 0 | 0 | 0 | 0 | 0 | 0 | 0 | 0 | 0 | 0 | 0 | 0 | 0 | 0 | 0 | 0 | 0 | 0 | 0 | 0 | 0 |
| SpindlePole | 1 | 0 | 1 | 1 | 4 | 2 | 3 | 5 | 1 | 1 | 0 | 2 | 0 | 1 | 2 | 5 | 8 | 4 | 5 | 0 | 0 | 2 | 3 | 4 |
| Vac/Vac Membrane | 2 | 4 | 6 | 0 | 3 | 1 | 0 | 0 | 4 | 0 | 5 | 2 | 3 | 2 | 3 | 22 | 37 | 26 | 14 | 14 | 7 | 31 | 48 | 44 |
| Unique Cell Count | 282 | 203 | 101 | 90 | 98 | 88 | 107 | 100 | 60 | 78 | 116 | 71 | 355 | 428 | 374 | 418 | 538 | 461 | 288 | 207 | 97 | 317 | 316 | 337 |
| Labelled Cell Count | 314 | 230 | 113 | 93 | 106 | 104 | 154 | 130 | 82 | 112 | 175 | 99 | 380 | 450 | 392 | 481 | 602 | 550 | 288 | 207 | 97 | 317 | 316 | 337 |
Yeast GFP Assignment
Protein Abundance
| Screen | WT1 | WT2 | WT3 | RAP60 | RAP140 | RAP220 | RAP300 | RAP380 | RAP460 | RAP540 | RAP620 | RAP700 | HU80 | HU120 | HU160 | rpd3Δ_1 | rpd3Δ_2 | rpd3Δ_3 | AF100 | AF140 | AF180 |
|---|---|---|---|---|---|---|---|---|---|---|---|---|---|---|---|---|---|---|---|---|---|
| Mean Cell GFP Intensity (1e-4) | 5.4 | 5.2 | 7.8 | 6.8 | 6.1 | 8.9 | 4.5 | 4.8 | 5.3 | 3.9 | 4.5 | 4.1 | 5.5 | 5.6 | 5.7 | 6.5 | 6.6 | 6.1 | 5.3 | 5.5 | 6.0 |
| Std Deviation (1e-4) | 1.1 | 0.9 | 5.7 | 3.8 | 2.0 | 9.4 | 1.4 | 1.8 | 4.5 | 1.5 | 3.0 | 1.0 | 1.1 | 1.4 | 1.6 | 1.3 | 1.3 | 1.3 | 1.3 | 1.3 | 1.9 |
| Intensity Change (Log2) | – | – | – | -0.19 | -0.34 | 0.19 | -0.8 | -0.71 | -0.56 | -1.0 | -0.8 | -0.94 | -0.5 | -0.49 | -0.46 | -0.27 | -0.24 | -0.35 | -0.54 | -0.49 | -0.37 |
Localization Change
| Localization | RAP60 | RAP140 | RAP220 | RAP300 | RAP380 | RAP460 | RAP540 | RAP620 | RAP700 | HU80 | HU120 | HU160 | rpd3Δ_1 | rpd3Δ_2 | rpd3Δ_3 |
|---|---|---|---|---|---|---|---|---|---|---|---|---|---|---|---|
| Cortical Patches | 0 | 0 | 0 | 0 | 0 | 0 | 0 | 0 | 0 | 0 | 0 | 0 | 0 | 0 | 0 |
| Bud | 0 | 0 | 0 | 0 | 0 | 0 | 0 | 0 | 0 | 0 | 0 | 0 | 0 | 0 | 0 |
| Bud Neck | 0 | 0 | 0 | 0 | 0 | 0 | 0 | 0 | 0 | 0 | 0 | 0 | 0 | 0 | 0 |
| Bud Site | 0 | 0 | 0 | 0 | 0 | 0 | 0 | 0 | 0 | 0 | 0 | 0 | 0 | 0 | 0 |
| Cell Periphery | 0 | 0 | 0 | 0 | 0 | 0 | 0 | 0 | 0 | 0 | 0 | 0 | 0 | 0 | 0 |
| Cytoplasm | 1.0 | 0.3 | 2.2 | 1.1 | 1.0 | 1.9 | -0.1 | -0.5 | 0.4 | -0.4 | 0.7 | 2.0 | 1.8 | 1.5 | 1.4 |
| Endoplasmic Reticulum | 0 | 0 | 0 | 0 | 0 | 0 | 0 | 0 | 0 | 0 | 0 | 0 | 0 | 0 | 2.5 |
| Endosome | 0 | 0 | 0 | 0 | 0 | 0 | 0 | 0 | 0 | 0 | 0 | 0 | 0 | 0 | 0 |
| Golgi | 0 | 0 | 0 | 0 | 0 | 0 | 0 | 0 | 0 | 0 | 0 | 0 | 0 | 0 | 0 |
| Mitochondria | 0 | 0 | 1.5 | 0 | 0 | 4.3 | 0 | 0 | 0 | 0.1 | 0 | 0 | 0.7 | -0.6 | 1.6 |
| Nucleus | -0.7 | -1.2 | -3.1 | -0.9 | -2.7 | -2.6 | -3.7 | -3.2 | -1.1 | 0.5 | -0.2 | -1.4 | -2.2 | -2.7 | -2.4 |
| Nuclear Periphery | 0 | 0 | 0 | 0 | 0 | 0 | 0 | 0 | 0 | 0 | 0 | 0 | 0 | 0 | 0 |
| Nucleolus | 0 | 0 | 0 | 0 | 0 | 0 | 0 | 0 | 0 | 0 | 0 | 0 | 0 | 0 | 0 |
| Peroxisomes | 0 | 0 | 0 | 0 | 0 | 0 | 0 | 0 | 0 | 0 | 0 | 0 | 0 | 0 | 0 |
| SpindlePole | 0 | 0 | 0 | 0 | 0 | 0 | 0 | 0 | 0 | 0 | 0 | 0 | 0 | 0 | 0 |
| Vacuole | 0 | 0 | 0 | 0 | 0 | 0 | 0 | -0.5 | 0 | 0 | 0 | 0 | -0.3 | 0.3 | -0.1 |
External localization resources
Images






























Protein Concentration and Protein Localization Data
| R1 | R2 | R3 | ||||||||||||||||
|---|---|---|---|---|---|---|---|---|---|---|---|---|---|---|---|---|---|---|
| G1 Pre-START | G1 Post-START | S/G2 | Metaphase | Anaphase | Telophase | G1 Pre-START | G1 Post-START | S/G2 | Metaphase | Anaphase | Telophase | G1 Pre-START | G1 Post-START | S/G2 | Metaphase | Anaphase | Telophase | |
| Concentration | 2.0822 | 2.8267 | 2.6138 | 2.6299 | 1.9534 | 2.6408 | 1.542 | 1.428 | 1.0152 | 0.8202 | 0.4036 | 0.8465 | 1.1943 | 1.2141 | 1.1311 | 1.5153 | 0.8654 | 1.066 |
| Actin | 0.0046 | 0 | 0.0045 | 0.0002 | 0.0257 | 0.0001 | 0.0194 | 0 | 0.0051 | 0.0011 | 0 | 0 | 0.0064 | 0 | 0.0059 | 0.0009 | 0 | 0.0004 |
| Bud | 0.0001 | 0 | 0.001 | 0.0003 | 0.0001 | 0 | 0.0019 | 0.0001 | 0.0002 | 0.0002 | 0.0001 | 0 | 0.0007 | 0 | 0.0006 | 0.0007 | 0 | 0.0002 |
| Bud Neck | 0.0008 | 0.0086 | 0.0007 | 0.0001 | 0.0016 | 0.0015 | 0.0032 | 0.0002 | 0.0048 | 0.0001 | 0.0007 | 0.0008 | 0.0052 | 0.0001 | 0.0013 | 0.0003 | 0.0003 | 0.001 |
| Bud Periphery | 0.0003 | 0.0001 | 0.0029 | 0.0004 | 0.0002 | 0 | 0.0065 | 0.0001 | 0.0003 | 0.0003 | 0.0001 | 0 | 0.0011 | 0 | 0.0005 | 0.0022 | 0 | 0.0009 |
| Bud Site | 0.0009 | 0.0095 | 0.0025 | 0.001 | 0.0006 | 0 | 0.0155 | 0.0004 | 0.0004 | 0.0007 | 0.0001 | 0.0001 | 0.0026 | 0 | 0.0016 | 0.0008 | 0 | 0.0001 |
| Cell Periphery | 0.0002 | 0.0003 | 0.0001 | 0.0001 | 0.0002 | 0 | 0.0009 | 0 | 0.0001 | 0 | 0 | 0 | 0.0003 | 0 | 0.0001 | 0.0004 | 0 | 0 |
| Cytoplasm | 0.0067 | 0.0001 | 0.0012 | 0.0002 | 0.0007 | 0.0044 | 0.0011 | 0.0011 | 0.0025 | 0.0001 | 0.001 | 0.0002 | 0.0132 | 0.0001 | 0.013 | 0.0412 | 0.0002 | 0.0019 |
| Cytoplasmic Foci | 0.0044 | 0 | 0.0034 | 0.0021 | 0.0082 | 0.0016 | 0.0108 | 0.0017 | 0.0009 | 0.001 | 0 | 0.0003 | 0.0161 | 0.0001 | 0.007 | 0.0045 | 0 | 0.0023 |
| Eisosomes | 0.0006 | 0 | 0.0001 | 0 | 0.0019 | 0.0001 | 0.0001 | 0 | 0 | 0.0001 | 0 | 0 | 0.0002 | 0 | 0.0001 | 0.0001 | 0 | 0 |
| Endoplasmic Reticulum | 0.0016 | 0 | 0.0006 | 0.0001 | 0.0017 | 0.0004 | 0.0028 | 0.0001 | 0.0006 | 0 | 0.0001 | 0 | 0.0109 | 0 | 0.0023 | 0.0011 | 0 | 0.0003 |
| Endosome | 0.0119 | 0 | 0.0054 | 0.0107 | 0.0094 | 0.0007 | 0.0259 | 0.004 | 0.0033 | 0.0011 | 0.0001 | 0.0057 | 0.0191 | 0 | 0.0096 | 0.0101 | 0 | 0.0043 |
| Golgi | 0.0043 | 0 | 0.003 | 0.0045 | 0.0062 | 0.0001 | 0.0158 | 0.0004 | 0.0044 | 0.0012 | 0 | 0.0017 | 0.0036 | 0 | 0.0036 | 0.0011 | 0 | 0.0003 |
| Lipid Particles | 0.0141 | 0 | 0.0056 | 0.0022 | 0.0064 | 0.006 | 0.0299 | 0.0001 | 0.0016 | 0.0029 | 0 | 0.0001 | 0.0196 | 0 | 0.0021 | 0.0052 | 0 | 0.0002 |
| Mitochondria | 0.0103 | 0.0001 | 0.0054 | 0.0378 | 0.0188 | 0.0002 | 0.0127 | 0.0003 | 0.0144 | 0.0259 | 0.0003 | 0.0004 | 0.0069 | 0.0001 | 0.0053 | 0.0349 | 0 | 0.0026 |
| None | 0.0319 | 0 | 0.0223 | 0.0003 | 0.0038 | 0.018 | 0.0005 | 0.0001 | 0.0155 | 0.0001 | 0.0001 | 0.0001 | 0.0095 | 0 | 0.0054 | 0.0011 | 0 | 0.0005 |
| Nuclear Periphery | 0.0106 | 0.0007 | 0.0031 | 0.0011 | 0.0104 | 0.0013 | 0.0105 | 0.0037 | 0.002 | 0.0006 | 0.005 | 0.0009 | 0.026 | 0.0008 | 0.0057 | 0.0025 | 0.0014 | 0.0035 |
| Nucleolus | 0.0097 | 0.0069 | 0.0073 | 0.0025 | 0.01 | 0.0191 | 0.012 | 0.0068 | 0.0052 | 0.004 | 0.0232 | 0.0181 | 0.0114 | 0.008 | 0.0059 | 0.0087 | 0.0271 | 0.0136 |
| Nucleus | 0.867 | 0.9721 | 0.9234 | 0.9291 | 0.8724 | 0.9354 | 0.8039 | 0.9767 | 0.9343 | 0.9554 | 0.9617 | 0.9697 | 0.7717 | 0.9092 | 0.8748 | 0.8186 | 0.9245 | 0.9278 |
| Peroxisomes | 0.0069 | 0 | 0.0043 | 0.0028 | 0.016 | 0.0007 | 0.0063 | 0.0001 | 0.0006 | 0.0046 | 0 | 0 | 0.0019 | 0 | 0.0014 | 0.001 | 0 | 0.0002 |
| Punctate Nuclear | 0.0109 | 0.0015 | 0.0018 | 0.0007 | 0.0046 | 0.0098 | 0.0074 | 0.0026 | 0.0024 | 0.0002 | 0.0065 | 0.0015 | 0.0651 | 0.0815 | 0.052 | 0.0482 | 0.0463 | 0.0383 |
| Vacuole | 0.0013 | 0.0001 | 0.0008 | 0.0026 | 0.0004 | 0.0004 | 0.0097 | 0.0012 | 0.0009 | 0.0002 | 0.0006 | 0.0002 | 0.0052 | 0 | 0.0008 | 0.0086 | 0 | 0.0006 |
| Vacuole Periphery | 0.0009 | 0 | 0.0004 | 0.0011 | 0.0007 | 0 | 0.0032 | 0.0002 | 0.0003 | 0.0002 | 0.0002 | 0.0002 | 0.0031 | 0 | 0.0008 | 0.0079 | 0 | 0.0009 |
Sequencing Data
| R1 | R2 | |||||||||
|---|---|---|---|---|---|---|---|---|---|---|
| G1 Post-START | S/G2 | Metaphase | Anaphase | Telophase | G1 Post-START | S/G2 | Metaphase | Anaphase | Telophase | |
| Gene Expression | 16.3467 | 11.3251 | 13.8254 | 16.2098 | 13.2464 | 12.2533 | 14.5905 | 15.8309 | 14.5752 | 18.3375 |
| Translational Efficiency | 0.7078 | 0.6922 | 0.7084 | 0.6657 | 0.8847 | 0.8107 | 0.5979 | 0.5503 | 0.7093 | 0.6227 |
Hit Data
| Dataset | Hit |
|---|---|
| Protein Concentration | ✘ |
| Protein Localization | ✘ |
| Gene Expression | ✘ |
| Translational Efficiency | ✘ |
Micrographs
































Cell Count
| R1 | R2 | R1 & R2 | |||||||||
|---|---|---|---|---|---|---|---|---|---|---|---|
| WT | UBP2 | UBP14 | UBP2UBP14 | WT | UBP2 | UBP14 | UBP2UBP14 | WT | UBP2 | UBP14 | UBP2UBP14 |
| 1563 | 1408 | 538 | 6 | 1572 | 1528 | 2066 | 7 | 3135 | 2936 | 2604 | 13 |
Protein Abundance
| R1 | R2 | R1 & R2 | ||||||||||
|---|---|---|---|---|---|---|---|---|---|---|---|---|
| WT | UBP2 | UBP14 | UBP2UBP14 | WT | UBP2 | UBP14 | UBP2UBP14 | WT | UBP2 | UBP14 | UBP2UBP14 | |
| Mean | 640.38 | 803.40 | 883.63 | 980.37 | 705.09 | 822.80 | 860.14 | 845.88 | 672.83 | 813.50 | 864.99 | 907.95 |
| Standard Deviation | 77.29 | 120.20 | 116.76 | 146.52 | 105.91 | 151.77 | 108.62 | 86.68 | 98.23 | 137.88 | 110.76 | 135.83 |
| Intensity Change Log 2 | — | 0.327190 | 0.464514 | 0.614398 | — | 0.222734 | 0.286764 | 0.262646 | — | 0.273394 | 0.374100 | 0.440774 |
Localization Score (DeepLoc)
| R1 | R2 | R1 & R2 | ||||||||||
|---|---|---|---|---|---|---|---|---|---|---|---|---|
| WT | UBP2 | UBP14 | UBP2UBP14 | WT | UBP2 | UBP14 | UBP2UBP14 | WT | UBP2 | UBP14 | UBP2UBP14 | |
| Actin | 0.000115 | 0.000426 | 0.000614 | 0.001868 | 0.000163 | 0.000228 | 0.000248 | 0.000408 | 0.000139 | 0.000323 | 0.000324 | 0.001082 |
| Bud Neck | 0.002320 | 0.009181 | 0.009654 | 0.005017 | 0.003040 | 0.007344 | 0.008814 | 0.001013 | 0.002681 | 0.008225 | 0.008988 | 0.002861 |
| Bud Site | 0.001375 | 0.001811 | 0.000666 | 0.000862 | 0.000655 | 0.000866 | 0.000839 | 0.000716 | 0.001014 | 0.001319 | 0.000803 | 0.000783 |
| Cell Periphery | 0.000229 | 0.000122 | 0.000038 | 0.000056 | 0.000167 | 0.000144 | 0.000057 | 0.000064 | 0.000198 | 0.000134 | 0.000053 | 0.000060 |
| Cytoplasm | 0.027453 | 0.007822 | 0.001798 | 0.002082 | 0.013152 | 0.008336 | 0.003133 | 0.032907 | 0.020282 | 0.008090 | 0.002858 | 0.018680 |
| Cytoplasmic Foci | 0.002685 | 0.001291 | 0.000019 | 0.000072 | 0.001942 | 0.001557 | 0.000126 | 0.000600 | 0.002313 | 0.001429 | 0.000104 | 0.000356 |
| Eisosomes | 0.000014 | 0.000017 | 0.000023 | 0.000049 | 0.000014 | 0.000014 | 0.000015 | 0.000032 | 0.000014 | 0.000016 | 0.000017 | 0.000040 |
| Endoplasmic Reticulum | 0.001471 | 0.004920 | 0.005150 | 0.023020 | 0.002811 | 0.004710 | 0.003538 | 0.006052 | 0.002143 | 0.004811 | 0.003871 | 0.013884 |
| Endosome | 0.000436 | 0.000712 | 0.000142 | 0.000355 | 0.000401 | 0.000537 | 0.000297 | 0.000745 | 0.000418 | 0.000621 | 0.000265 | 0.000565 |
| Golgi | 0.000215 | 0.000684 | 0.000044 | 0.000069 | 0.000114 | 0.000359 | 0.000229 | 0.000066 | 0.000165 | 0.000515 | 0.000191 | 0.000068 |
| Lipid Particles | 0.000895 | 0.000398 | 0.000069 | 0.000461 | 0.000337 | 0.000427 | 0.000115 | 0.000421 | 0.000615 | 0.000413 | 0.000106 | 0.000440 |
| Mitochondria | 0.002038 | 0.002941 | 0.000747 | 0.001345 | 0.000851 | 0.002559 | 0.000924 | 0.000463 | 0.001443 | 0.002742 | 0.000887 | 0.000870 |
| Mitotic Spindle | 0.001955 | 0.003538 | 0.000362 | 0.001329 | 0.000235 | 0.005621 | 0.003292 | 0.000800 | 0.001092 | 0.004622 | 0.002687 | 0.001044 |
| None | 0.022062 | 0.004988 | 0.002814 | 0.000655 | 0.012554 | 0.003082 | 0.001750 | 0.001624 | 0.017294 | 0.003996 | 0.001970 | 0.001177 |
| Nuclear Periphery | 0.000667 | 0.000927 | 0.001110 | 0.001397 | 0.000775 | 0.001735 | 0.000647 | 0.001038 | 0.000721 | 0.001348 | 0.000743 | 0.001204 |
| Nuclear Periphery Foci | 0.000400 | 0.000564 | 0.000504 | 0.000087 | 0.000390 | 0.000465 | 0.000109 | 0.000524 | 0.000395 | 0.000513 | 0.000191 | 0.000322 |
| Nucleolus | 0.007461 | 0.006002 | 0.005863 | 0.001876 | 0.009095 | 0.006321 | 0.001990 | 0.004495 | 0.008281 | 0.006168 | 0.002790 | 0.003286 |
| Nucleus | 0.926638* | 0.950211* | 0.969285* | 0.946354* | 0.951954* | 0.952518* | 0.972172* | 0.918507* | 0.939332* | 0.951412* | 0.971576* | 0.931360* |
| Peroxisomes | 0.000687 | 0.001132 | 0.000159 | 0.000367 | 0.000351 | 0.000373 | 0.000073 | 0.000130 | 0.000519 | 0.000737 | 0.000091 | 0.000240 |
| Vacuole | 0.000743 | 0.001967 | 0.000853 | 0.012504 | 0.000784 | 0.002036 | 0.001373 | 0.029296 | 0.000764 | 0.002003 | 0.001266 | 0.021546 |
| Vacuole Periphery | 0.000140 | 0.000345 | 0.000084 | 0.000176 | 0.000213 | 0.000769 | 0.000257 | 0.000098 | 0.000177 | 0.000566 | 0.000221 | 0.000134 |
Localization Changes (T-score)
| R1 | R2 | R1 & R2 | |||||||||||||
|---|---|---|---|---|---|---|---|---|---|---|---|---|---|---|---|
| UBP2_WT | UBP14_WT | UBP2UBP14_WT | UBP2UBP14_UBP2 | UBP2UBP14_UBP14 | UBP2_WT | UBP14_WT | UBP2UBP14_WT | UBP2UBP14_UBP2 | UBP2UBP14_UBP14 | UBP2_WT | UBP14_WT | UBP2UBP14_WT | UBP2UBP14_UBP2 | UBP2UBP14_UBP14 | |
| Actin | NaN | NaN | NaN | NaN | NaN | NaN | NaN | NaN | NaN | NaN | NaN | NaN | NaN | NaN | NaN |
| Bud Neck | NaN | NaN | NaN | NaN | NaN | NaN | NaN | NaN | NaN | NaN | NaN | NaN | NaN | NaN | NaN |
| Bud Site | NaN | NaN | NaN | NaN | NaN | NaN | NaN | NaN | NaN | NaN | NaN | NaN | NaN | NaN | NaN |
| Cell Periphery | NaN | NaN | NaN | NaN | NaN | NaN | NaN | NaN | NaN | NaN | NaN | NaN | NaN | NaN | NaN |
| Cytoplasm | NaN | NaN | NaN | NaN | NaN | NaN | NaN | NaN | NaN | NaN | NaN | NaN | NaN | NaN | NaN |
| Cytoplasmic Foci | NaN | NaN | NaN | NaN | NaN | NaN | NaN | NaN | NaN | NaN | NaN | NaN | NaN | NaN | NaN |
| Eisosomes | NaN | NaN | NaN | NaN | NaN | NaN | NaN | NaN | NaN | NaN | NaN | NaN | NaN | NaN | NaN |
| Endoplasmic Reticulum | NaN | NaN | NaN | NaN | NaN | NaN | NaN | NaN | NaN | NaN | NaN | NaN | NaN | NaN | NaN |
| Endosome | NaN | NaN | NaN | NaN | NaN | NaN | NaN | NaN | NaN | NaN | NaN | NaN | NaN | NaN | NaN |
| Golgi | NaN | NaN | NaN | NaN | NaN | NaN | NaN | NaN | NaN | NaN | NaN | NaN | NaN | NaN | NaN |
| Lipid Particles | NaN | NaN | NaN | NaN | NaN | NaN | NaN | NaN | NaN | NaN | NaN | NaN | NaN | NaN | NaN |
| Mitochondria | NaN | NaN | NaN | NaN | NaN | NaN | NaN | NaN | NaN | NaN | NaN | NaN | NaN | NaN | NaN |
| Mitotic Spindle | NaN | NaN | NaN | NaN | NaN | NaN | NaN | NaN | NaN | NaN | NaN | NaN | NaN | NaN | NaN |
| None | NaN | NaN | NaN | NaN | NaN | NaN | NaN | NaN | NaN | NaN | NaN | NaN | NaN | NaN | NaN |
| Nuclear Periphery | NaN | NaN | NaN | NaN | NaN | NaN | NaN | NaN | NaN | NaN | NaN | NaN | NaN | NaN | NaN |
| Nuclear Periphery Foci | NaN | NaN | NaN | NaN | NaN | NaN | NaN | NaN | NaN | NaN | NaN | NaN | NaN | NaN | NaN |
| Nucleolus | NaN | NaN | NaN | NaN | NaN | NaN | NaN | NaN | NaN | NaN | NaN | NaN | NaN | NaN | NaN |
| Nucleus | NaN | NaN | NaN | NaN | NaN | NaN | NaN | NaN | NaN | NaN | NaN | NaN | NaN | NaN | NaN |
| Peroxisomes | NaN | NaN | NaN | NaN | NaN | NaN | NaN | NaN | NaN | NaN | NaN | NaN | NaN | NaN | NaN |
| Vacuole | NaN | NaN | NaN | NaN | NaN | NaN | NaN | NaN | NaN | NaN | NaN | NaN | NaN | NaN | NaN |
| Vacuole Periphery | NaN | NaN | NaN | NaN | NaN | NaN | NaN | NaN | NaN | NaN | NaN | NaN | NaN | NaN | NaN |
Endocytosis
| Temp | Actin Patch (Sac6-tdTomato) | Cortical Patch (Sla1-GFP) | Late Endosome (Snf7-GFP) | Vacuole (Vph1-GFP) |
|---|---|---|---|---|
| 37℃ | ||||
| RT |
Cell Cycle Omics
CYCLoPs (Prp6-GFP)
| Gene / Allele | Actin Patch (Sac6-tdTomato) | Cortical Patch (Sla1-GFP) | Late Endosome (Snf7-GFP) | Vacuole (Sac6-tdTomato) |
|---|
| Gene | Images |
|---|
| Gene | Images |
|---|
Images are not yet available
Images are not yet available